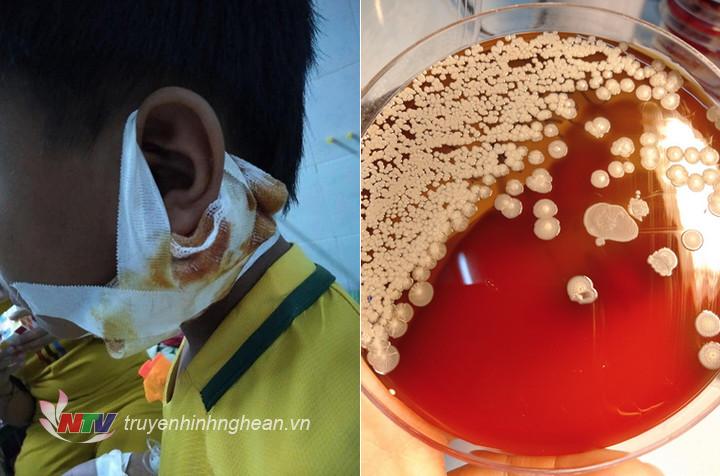

Giảm nguy cơ xơ vữa động mạch bằng ăn uống
Để dự phòng, chế độ ăn uống và sinh hoạt chiếm vai trò hết sức quan trọng. Dưới đây là một số lưu ý ăn uống dự phòng cho người bị xơ vữa động mạch vành.
Những lối sống gây nguy cơ xơ vữa
Thiếu vận động: Cuộc sống ít vận động và thiếu hoạt động thể chất và tập thể dục làm bạn có nguy cơ thừa cân, cholesterol trong máu cao và phát triển tăng huyết áp, đái tháo đường. Điều này “góp phần” gây mảng bám trong lòng động mạch và gây hậu quả nghiêm trọng.
Chế độ ăn uống nhiều cholesterol: Thịt, trứng, pho mát và các sản phẩm sữa nguyên kem chứa nhiều cholesterol có thể là lý do để hình thành mảng bám trong động mạch.
Chất béo bão hòa: Một trong các thủ phạm chính trong chế độ ăn uống dẫn đến mảng bám tích tụ trong động mạch và gây xơ vữa động mạch là chất béo bão hòa. Ăn nhiều chất béo bão hòa, có thể dẫn đến các vấn đề nghiêm trọng cho sức khỏe. Các thực phẩm giàu chất béo bão hòa là: bơ; các sản phẩm sữa nhiều chất béo; phô mai; thịt chế biến công nghiệp; một số loại dầu như dầu cọ. Cố gắng giới hạn việc ăn những thức ăn này để giảm nguy cơ hình thành mảng bám.
Chất béo chuyển hóa: Chất béo chuyển hóa là những chất béo do con người tạo ra trong nhiều loại thực phẩm. Những chất này làm tăng hương vị và kết cấu của thức ăn nhưng gây tổn hại cho động mạch và có thể lắng đọng dưới dạng mảng bám trong động mạch. Thực phẩm chế biến sẵn có nhiều chất béo chuyển hóa và nên hạn chế dùng chúng. Tốt hơn là đọc nhãn một cách cẩn thận để tránh tiêu thụ quá nhiều chất béo chuyển hóa gây hại này.
Hút thuốc lá: Hút thuốc rất có hại cho sức khỏe. Chất nicotin tìm thấy trong thuốc lá có thể làm hỏng lớp áo động mạch và các động mạch bị tổn thương dễ dàng phát triển các mảng bám. Để tránh rủi ro nghiêm trọng này, hãy bỏ hút thuốc. Bỏ hút thuốc cũng sẽ ngăn cản bạn khỏi nhiều biến chứng sức khỏe khác.

Những thực phẩm hữu ích ngăn ngừa
Ngoài việc thay đổi lối sống tích cực như đã đề cập trên, dưới đây là một số thực phẩm có thể hữu ích để ngăn ngừa và thậm chí loại bỏ sự tích tụ mảng bám.
Măng tây: Măng tây có nhiều chất xơ, vitamin và khoáng chất. Măng tây có tác dụng làm giảm huyết áp. Vitamin C, E, K, B1 và B2 có trong măng tây rất hữu ích trong việc duy trì các động mạch khỏe mạnh.
Trái bơ: Nằm trong danh sách các món ăn có lợi cho động mạch. Bơ có nhiều chất béo tốt và rất có lợi cho sức khỏe. Bơ có vị ngon và giầu chất xơ, vitamin, chất chống oxy hóa, chất béo tốt và khoáng chất. Bơ có khả năng làm giảm mức cholesterol trong máu đáng kể và cũng làm tăng “cholesterol tốt” HDL trong máu. HDL có thể lấy cholesterol từ các động mạch mang trả về gan xử lý, và có khả năng loại bỏ các mảng bám xơ vữa trong động mạch.
Bông cải xanh: Mức vitamin K cao trong bông cải xanh rất tốt cho việc duy trì các động mạch khỏe mạnh. Bông cải xanh cũng chứa nhiều vitamin và khoáng chất khác và có thể làm hạ thấp mức “cholesterol xấu” LDL. Bông cải xanh có nhiều chất xơ và cũng có thể làm giảm huyết áp. Những yếu tố này hữu ích trong việc ngăn ngừa hình thành mảng bám và có thể làm giảm nguy cơ phát triển bệnh tim mạch nghiêm trọng.
Những quả mọng: Những loại quả mọng có rất nhiều chất chống oxy hóa. Chất chống oxy hóa làm tăng HDL trong máu. Bổ sung quả mọng vào chế độ ăn uống hàng ngày có thể làm giảm nguy cơ xơ vữa động mạch và nhiều bệnh khác.
Cá béo nước lạnh: Cá nước lạnh (cá ngừ, cá hồi, cá thu và cá mòi...) được biết đến là một phần của chế độ ăn uống để làm “sạch” các động mạch. Loại cá này chứa chất béo tốt và rất hữu ích để giảm viêm và mảng bám tích tụ trong các mạch máu. Nên ăn hai lần mỗi tuần để có sức khỏe tim mạch tốt.
Các loại hạt: Hạt dẻ là lựa chọn ăn vặt lành mạnh nhất, có chứa vitamin E và chất béo không bão hòa đơn. Hạnh nhân rất tốt đối với sức khỏe tim mạch. Óc chó và hạt lanh cũng là những lựa chọn tốt để tăng sức khỏe và giảm tỷ lệ viêm và giảm hình thành mảng bám trong động mạch.
Tóm lại, tăng huyết áp, nồng độ đường máu cao, ăn quá nhiều chất béo xấu, thừa cân béo phì, phong cách sống tĩnh tại, hút thuốc lá, uống nhiều rượu bia là những nguyên nhân gây ra mảng bám xơ vữa trong động mạch của bạn. Để tránh xơ vữa động mạch cần thay đổi lối sống tích cực và chọn chế độ ăn uống lành mạnh.

Thông tin bạn đọc
Đóng Lưu thông tin